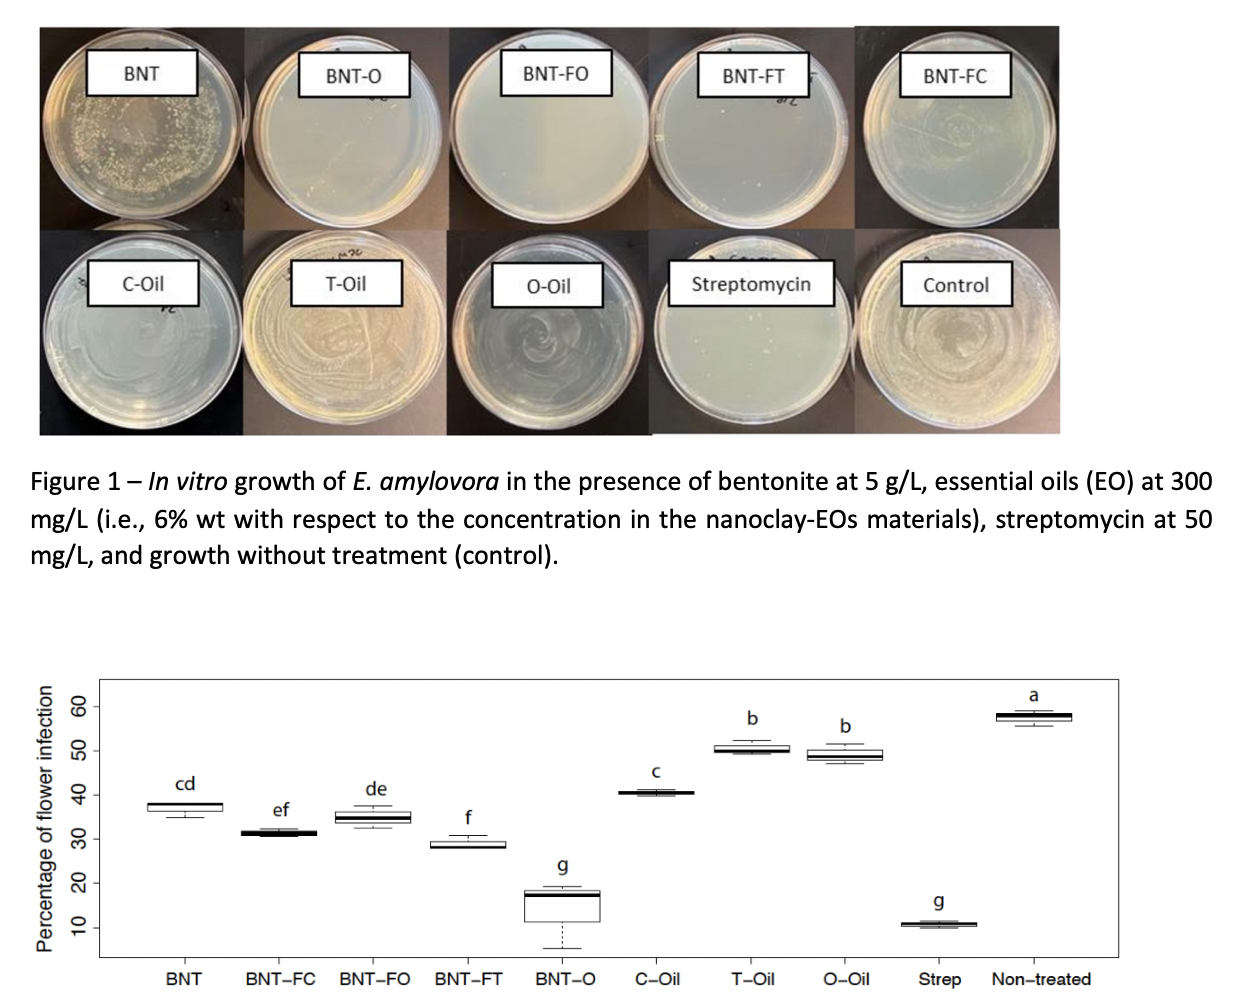

SUNSHINE International Collaboration Activities: Part II
Collaboration with the Connecticut Agricultural Experiment Station
UNIVE (Italy): Professor Antonio Marcomini and Dr. Andrea Brunelli
CSIC (Spain): Professor Josè F. Fernandez
ENCAPSULAE (Spain): Dr. Javier Menéndez, Dr. Castor Salgado
CAES (US): Dr. Jason C. White, Dr. Quan Zeng
Background
The application of nanotechnology in agriculture is a promising tool to address challenges in food production. Conventional agricultural practices include extensive loads of agrichemicals to cope with the high incidence of disease among other food crops’ stressors. Unfortunately, the use of these agrichemicals is very inefficient, often with less than 10% being utilized by plants. Therefore, growers need to overapply amounts of fertilizers and pesticides to ensure desired performance or to use unsustainable measures such as antibiotics in fruit trees to control bacterial diseases. Nano-formulations represent an option to reduce the utilization of conventional agrochemicals. In this context, nanomaterials can be effective and sustainable sources of nutrients or can be carriers of active ingredients that trigger a response in the host, for example to inhibit replication of microorganisms like bacteria.
Results of the EU-US joint collaboration
The main aim of this collaboration, among UNIVE, CSIC-ENCAPSULAE and CAES, is the antimicrobial activity assessment of the multi-component nanomaterials (i.e., nanoclays functionalized with essential oils) developed by CSIC-ENCAPSULAE, against Erwinia amylovora, a bacterial pathogen which is responsible of fire blight, one of the most important diseases of apple and pear in the United States and worldwide.
Both in vitro and field experimental activities were performed by Dr. Andrea Brunelli (UNIVE) during his visit to the CAES Lockwood farm (Hamden, CT, US) for 45 days in spring 2023, under the supervision of Dr. Quan Zeng and Dr. Jason White. The in vitro assays showed the higher inhibition against E. amylovora Ea110 for BNT-O, BNT-F-O, BNT-F-T (Figure 1).
Based on the in vitro results, all the samples listed in Table 1 were also tested at an apple orchard at the Lockwood farm to determine whether nanoclays enhance the antimicrobial efficacy of essential oil on apple flowers and overall fire blight infection under field conditions. The field results in Figure 2 showed that BNT-O prevented infection with roughly equivalent efficacy to that of the antibiotic streptomycin. This is a significant and promising result, as it demonstrates that it is possible to move away from the use of antibiotics in agriculture. Moreover, it is worth noting that, although efficiency was sometimes lower, all treatments with BNT and EO had some impact on reducing infection in comparison to the control (no treatment at all).
Further steps
Taking into account the promising preliminary results obtained through this collaboration, a further field testing next spring (2024) at Lockwood farm would be useful to confirm the efficacy of the MCNMs to prevent the spread of fire blight.
—————————————————————————————————————————————————————————————-
SUNSHINE and INFRAMES have a long collaboration history initiated within the International Collaboration Work Package (WP) of SUNSHINE. Facilitated by the WP Leader Dr Lang Tran and the SUNSHINE Coordinator, Dr Danail Hristozov, numerous collaboration routes such as oversees staff exchange and knowledge transfer opportunities were designed and further open up to other EU funded projects working on (nano-) safety and sustainability of advanced materials.
“The synergies between the international communities in INFRAMES and SUNSHINE are numerous. Our hope is that, in coming together as a single community in Venice, we have planted the seed for broader, long-term collaborations that will address the challenges posed by new materials such as nanomaterials”
- Dr Mark Wiesner
“We were able to foster a fruitful scientific collaboration building a truly international community working on topics of high societal and environmental impact”
- Dr Danail Hristozov
About SUNSHINE
SUNSHINE is an industry-oriented project, where leading research and technology organisations cooperate with SMEs and large industries to develop and implement simple, robust, and cost-effective Safe-and-Sustainable-by-Design (SSbD) strategies for materials and products based on advanced multi-component nanomaterials. To this end, the project has established a user-friendly e-infrastructure as a digital hub to foster dialogue, collaboration, and information exchange between actors along entire product supply chains to support SSbD decision making and prototyping.
About INFRAMES
INFRAMES (International Network for Researching, Advancing, and Assessing Materials for Environmental Sustainability) leverages the substantial investments in US and EU networks in the area of environmental nanotechnology to assemble a coordinated international community of researchers dedicated to assessing the sustainability of the materials our society produces. INFRAMES includes 18 US universities associated with the Center for the Environmental Implications of NanoTechnology (CEINT) and the Center for Sustainable Nanotechnology (CSN), along with networks representing over 100 participating EU and UK partners, the Kwame Nkrumah University of Science and Technology (KNUST) in Ghana, and researchers at six synchrotron X-ray facilities in four countries.